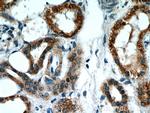
BBS4 Antibody in Immunohistochemistry (Paraffin) (IHC (P))

Search
Proteintech
BBS4 Polyclonal Antibody
{{$productOrderCtrl.translations['antibody.pdp.commerceCard.promotion.promotions']}}
{{$productOrderCtrl.translations['antibody.pdp.commerceCard.promotion.viewpromo']}}
{{$productOrderCtrl.translations['antibody.pdp.commerceCard.promotion.promocode']}}: {{promo.promoCode}} {{promo.promoTitle}} {{promo.promoDescription}}. {{$productOrderCtrl.translations['antibody.pdp.commerceCard.promotion.learnmore']}}
产品信息
12766-1-AP
种属反应
已发表种属
宿主/亚型
分类
类型
抗原
偶联物
形式
浓度
规格
纯化类型
保存液
内含物
保存条件
运输条件
产品详细信息
Immunogen sequence: MAEERVATR TQFPVSTESQ KPRQKKAPEF PILEKQNWLI HLHYIRKDYE ACKAVIKEQL QETQGLCEYA IYVQALIFRL EGNIQESLEL FQTCAVLSPQ SADNLKQVAR SLFLLGKHKA AIEVYNEAAK LNQKDWEISH NLGVCYIYLK QFNKAQDQLH NALNLNRHDL TYIMLGKIHL LEGDLDKAIE VYKKAVEFSP ENTELLTTLG LLYLQLGIYQ KAFEHLGNAL TYDPTNYKAI LAAGSMMQTH GDFDVALTKY RVVACAVPES PPLWNNIGMC FFGKKKYVAA ISCLKRANYL APFDWKILYN LGLVHLTMQQ YASAFHFLSA AINFQPKMGE LYMLLAVALT NL (1-351 aa encoded by BC027624)
靶标信息
BBS4 contains tetratricopeptide repeats (TPR), similar to O-linked N-acetyglucosamine transferase. Mutations in the gene encoding this protein have been observed in patients with Bardet-Biedl syndrome type 4. BBS4 may play a role in pigmentary retinopathy, obesity, polydactyly, renal malformation and mental retardation.
仅用于科研。不用于诊断过程。未经明确授权不得转售。
生物信息学
蛋白别名: Bardet-Biedl syndrome 4 homolog; Bardet-Biedl syndrome 4 protein; Bardet-Biedl syndrome 4 protein homolog; BBS4; BBSome complex member BBS4; unnamed protein product
基因别名: AW537059; AW742241; BBS4; D9Ertd464e
UniProt ID: (Human) Q96RK4, (Mouse) Q8C1Z7
Entrez Gene ID: (Human) 585, (Mouse) 102774, (Rat) 300754